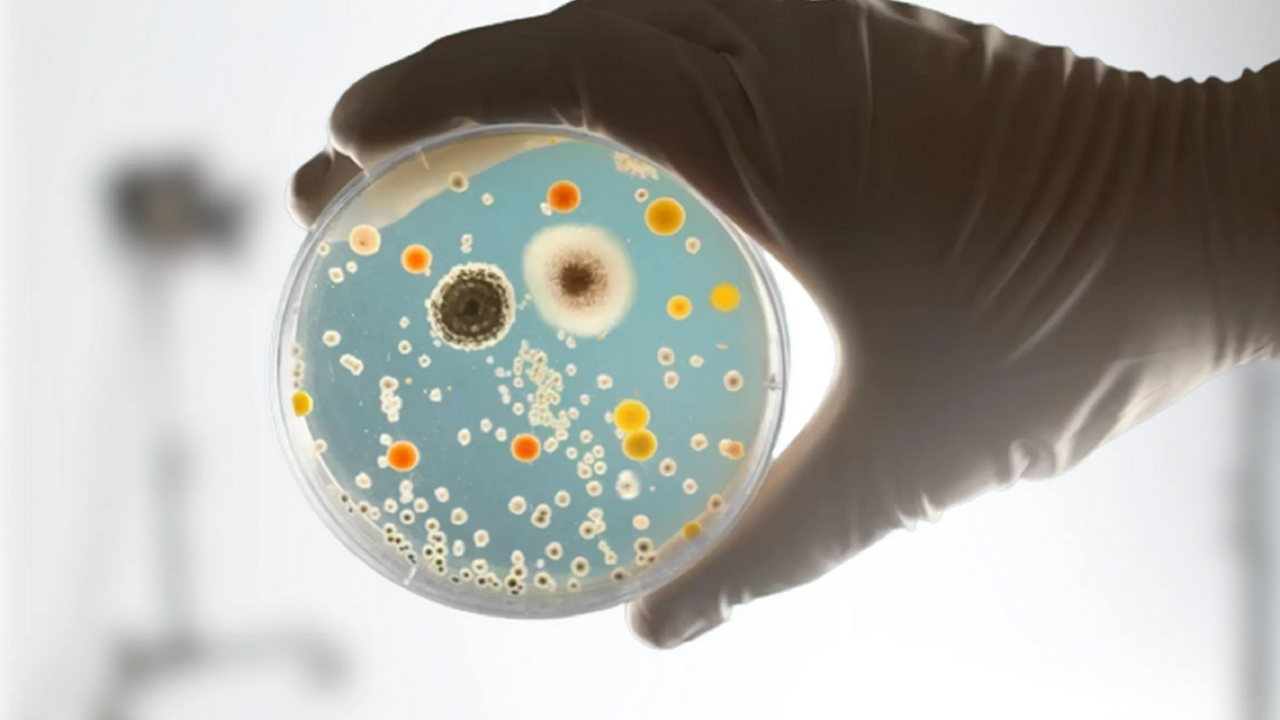
¿Qué es la “súper gonorrea” y por qué causa alerta en EU?

La "súper gonorrea" es una enfermedad de transmisión sexual que es resistente a los medicamentos.
Foto: diariodesevilla.
es.
súper gonorreaenfermedad de transmisión sexual que no se puede combatir con medicamentos, pues es muy resistente, por ese motivo los Estados UnidosEU) lanzaron una alerta para informar a los norteamericanos, ¡aquí te damos los detalles!las noticias te revelamos qua los Centros para el Control y la Prevención de Enfermedades revelaron que cada año se registra hasta 1.
6 millones de personas contagiadas y que al menos el 50% de los casos no tienen cura.
Hace poco te contamos cuáles son los síntomas de esta enfermedad, pero ahora, te indicamos que se creó una campaña por parte de la AIDS Healthcare Foundation para informar a los ciudadanos de EU sobre su peligro y así, tratar de contener su propagación.
Hace poco en Massachusetts, médicos dieron a conocer que había dos casos de personas que tenían “súper gonorrea” y que los medicamentos que normalmente actúan para curar esta enfermedad no eran efectivos, sobre esto, el doctor y profesor de salud pública en la Universidad del Sur de California, Jeffrey Klausner, indicó:.
“Es un recordatorio de que la gonorrea se está volviendo cada vez más resistente, cada vez más difícil de tratar.
No tenemos nuevos antibióticos.
”.
Además, señaló que a pesar de que existe una inyección de ceftriaxona que parece poder combatir esta enfermedad, no se sabe por cuánto tiempo seguirá siendo efectiva, por ello, indicó:.
“No hemos tenido nuevos antibióticos para tratar la gonorrea durante años, y realmente necesitamos una estrategia de tratamiento diferente.
”.
Cabe mencionar que para asegurarse de que se tiene esta enfermedad se tiene que realizar un estudio donde la muestra se toma con un hisopo directamente del área enferma o por medio del análisis de orina.
¡Síguenos en Twitter para mantenerte informado con las noticias de hoy!.
Síguenos en Facebook y entérate de las noticias trend de la semana


No hay comentarios.:
Publicar un comentario